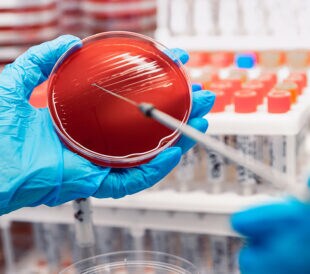
Microbial culture is traditionally the gold standard for the detection of many infectious pathogens. Molecular diagnostics can detect organisms missed by routine culture.

Increase in Oropouche Virus Disease Shines Spotlight on Arbovirus Threats Worldwide

Double Detection: The Case for Including Wound Testing in UTI Labs

Closing the Respiratory Tract Infections Diagnostic Gap with PCR-based Testing

ASM Microbe 2023: To Chase or Not to Chase Every Pathogen

How to Build Infectious Disease Molecular Panels That Are Clinically Relevant and Payor-Supported
Is it time to substitute culture with molecular diagnostics for infectious diseases?

Infectious Gastroenteritis: Molecular Testing to Get Ahead of Outbreaks
